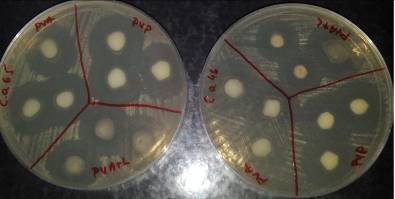

Etapa I/decembrie 2012
În cadrul primei
etape de derulare a proiectului s-au realizat integral obiectivele şi
activităţile propuse. Dintre rezultatele majore ale proiectului se
pot enumera următoarele:
|
-
realizarea
unei minicolecţii de tulpini bacteriene şi fungice izolate din
infecţii cu producere de biofilme asociate dispozitivelor protetice
tubulare; |
Imagini SEM caracteristice: a)
secţiune prin cateter; b) dezvoltarea biofilmului pe suprafaţa
recepturii de PVC |
|
-
stabilirea
unor profiluri detaliate de virulenţă şi rezistenţa la antibiotice
a acestor tulpini, la nivel fenotipic şi molecular; |
|
|
-
s-au
selectat polimerii ce se vor utiliza în etapele următoare; |
|
|
-
s-au
elaborat recepturi şi s-au stabilit condiţiile tehnologice pentru
obţinerea eşantioanelor standardizate pentru realizarea
dispozitivelor protetice tubulare medicale; |
|
|
-
s-au realizat studii şi analize privind proprietăţile
fizico-mecanice ale materialelor experimentale şi a diverşilor
parametrii fizico-chimici şi morfologici ai suprafeţelor
obţinute; |
|
|
-
aceste rezultate au făcut obiectul unui amplu raport de fază
precum şi a unui număr impresionant de articole (>10 articole
ISI) şi participarea la o conferinţă. |
Etapa 2/decembrie 2013
În cadrul
etapei curente s-a urmărit obţinerea unor modele experimentale de
dispozitive protetice tubulare stratificate cu proprietăţi
antibiofilm. O atenţie deosebită s-a acordat obţinerii,
caracterizării şi testării modelelor experimentale de tip PVC/PE
deoacere, inalta hidrofobie a PE permite fixarea problematică a
microorganismelor pe suprafaţă. De asemenea, au fost obţinute
şi diverse materiale pornind de la cele două sorturi de PVC medical
RB1 şi RB3 prin funcţionalizare pe suprafaţă. În acest
sens, cele două torturi de PVC au fost imersate în diverse soluţii
care să permită functionalizarea suprafetei de PVC (NaOH şi AgNO3
diverse condiţii). Materialele astfel obţinute au fost caracterizare
prin tehnici adecvate dintre care se va menţiona doar microscopia FTIR, o
tehnica relativ puţin cunoscută dar care a permis obţinerea unor
informaţii deosebit de utile privind interfaţa PVC/PE sau
distribuţia anumiter elemente pe suprafaţă, etc.
Pentru realizarea dispozitivelor medicale
stratificate s-a tinut cont de utilizarea in contact cu corpul uman pe durate
prelungite. Din acest motiv au fost selectate urmatoarele sorturi de PVC de uz
medical, codificate RB1 si RB3 (plastifiat cu di-2 etil-hexil-ftalat),
Materialul RB1 este mai
viscos in topitura, are o compozitie mai compacta deoarece cantitatea de plastifiant
este mai mica decat in materialul RB3. Ca urmare, asa cum era de asteptat,
materialul RB1 este putin mai rigid (prezinta duritate si rezistenta la
tractiune mai mare), prezinta flexibilitate mai mica (proprietati de alungire
si elasticitate) fata de materialul RB3. Acest lucru se observa din valorile
tuturor proprietatilor mecanice expuse in de mai jos. Diferentele dintre valori
nu sunt mari, ele reflecta posibilitatea utilizarii celor doua materiale pentru
aplicatii in dispozitive medicale diferite ca forma si utilizare.
Dupa imbatranirea accelerata
la 70oC timp de 168 ore, RB1 si RB3 sufera usoare modificari
morfologice, ceea ce se reflecta prin scaderea proprietatilor mecanice impuse
de domeniul de aplicare.
Absorbtia de apa in
compoundurile RB1 si RB3 este aproape nula.
Migrarea plastifiantului
prezinta valori extrem de mici, ceea ce conduce la observatia ca materialele
RB1 si RB3 nu cedeaza plastifiant in corpul uman deci sunt biocompatibile.
Valorile proprietatilor mecanice pentru
probele RB1 si RB3
|
Nr. Crt. |
Caracteristici, UM |
RB1 |
RB3 |
Standard metoda de analiza |
|
|
1. |
Duritate, oShA |
91 |
87 |
SR EN ISO 868:2003 |
|
|
2. |
Elasticitate, % |
6 |
6 |
SR EN ISO 527-3:2000 |
|
|
3. |
Modul N/mm2 |
100% |
10,8 |
9,8 |
SR EN ISO 527-3:2000 |
|
300% |
18 |
16,3 |
SR EN ISO 527-3:2000 |
||
|
4. |
Rezistenta la
tractiune, N/mm2 |
20,2 |
19,2 |
SR EN ISO 527-3:2000 v=200mm/min Epruvete tip 5 |
|
|
5. |
Alungirea la
rupere, % |
380 |
413 |
SR EN ISO 527-3:2000 v=200mm/min |
|
|
6. |
Alungirea
remanenta, % |
72 |
80 |
SR EN ISO 527-3:2000 v=200mm/min |
|
|
7. |
Rezistenta la
sfasiere, N/mm |
98,5 |
100 |
SR EN ISO 527-3:2000 v=200mm/min |
|
|
8. |
Densitate, g/cm3 |
1,25 |
1,24 |
SR EN ISO 1183-1:2004 |
|
|
9. |
Uzura, mm3 |
98 |
100 |
SR EN ISO 4649/2010 |
|
|
10. |
Punct de
inmuiere Vicat, oC |
55 |
51 |
SR EN ISO 306/2005 |
|
|
11. |
Rezistenta la
soc Charpy, kJ/m2 |
0,4 |
0,48 |
SR EN ISO 179/2001 |
|
|
12. |
Duritate Shore, oShA |
89 |
87 |
SR EN ISO 868:2003 |
|
|
13. |
Absorbtia de apa,
% |
0,0004 |
0,0005 |
SR EN ISO 62: 2004 Metoda 1 |
|
|
14. |
Migrarea
plastifiantului, g |
0,02 |
|
SR EN ISO 177/19 |
|
|
Imbatranire accelerata 70oC, 168 ore |
|||||
|
1. |
Duritate, oShA |
91 |
87 |
SR EN ISO
868:2003 |
|
|
2. |
Elasticitate, % |
7 |
6 |
SR EN ISO
527-3:2000 |
|
|
3. |
Modul, N/mm2 100% Modul, N/mm2 |
10,3 16,3 |
9,5 15,8 |
SR EN ISO
527-3:2000 |
|
|
4. |
Rezistenta la tractiune, N/mm2 |
19 |
17,4 |
SR EN ISO
527-3:2000 v=200mm/min Epruvete tip 5 |
|
|
5. |
Alungirea la rupere, % |
420 |
380 |
SR EN ISO
527-3:2000 v=200mm/min |
|
|
6. |
Alungirea remanenta, % |
96 |
98 |
SR EN ISO
527-3:2000 v=200mm/min |
|
|
7. |
Rezistenta la sfasiere, N/mm2 |
117 |
90,5 |
SR EN ISO
527-3:2000 v=200mm/min |
|
În cazul
probelor PVC/PE au fost analizate prin FTIR după o prealabilă
desprindere parţială a celor două straturi (dispersia
radiaţiei şi grosimea foarte mică a PE fac problematică
identificarea polietilenei. Prin monitorizarea adecvată se pot pune în
evidenţă cele două straturi aferente PVC (1723cm-1)
şi respectiv PE (2920cm-1). În aceste condiţii se poate
lesne identifica stratul de PVC şi stratul de PE.
|
Monitorizarea distributiei
PVC |
Monitorizarea distributiei
PE |
|
|
|
Studiul aderentei celulelor epiteliale la diferitele suprafeţe polimerice
Capacitatea de aderenţă la suprafaţa
biomaterialelor testate a celulelor
epiteliale reprezentate de linia celulara Hep-2 a fost apreciată prin vizualizarea monostratului celular la microscopul inversat.

Fig. Aspectul microscopic al celulelor epiteliale aderate la suprafaţa biomaterialelor (microscop inversat, 200x) (a. RB1; b. RB3; c. PE)
Etapa 3/decembrie 2014
Scopul acestei etape a fost realizarea de nanoparticule de Ag adecvate pentru inglobarea in polimer (PVC) precum şi obtinerea de dispozitive tubulare stratificate cu proprietati antimicrobiene, utilizand tehnologiile de prelucrare in topitura prin coextrudare si extrudare a unor recepturi de PVC plastifiat.
Pentru efectuarea acestor lucrari, intr-o prima etapa au fost selectate materiile prime necesare obtinerii de recepturi polimerice si anume: PVC pulbere cu K-vert 70 si absorbtie de plastifiant 144%, trei tipuri de plastifianti: adipat, citrate si ftalat (DOP), lubrifiant ulei de soia epoxidat, stabilizatori termici, antioxidant, doua tipuri de agent antimicrobian incapsulate in material ceramic si in copolimer etilen vinilacetat.
In vederea prelucrarii prin coextrudare au fost efectuate urmatoarele modele experimentale:
- Realizare recepturi de PVC plastifiat cu cele trei tipuri de plastifianti codificate P1m, P2m, RB, P1S3, P1B2, P2S3, P2B2, RBS3, RBB2 la nivel laborator si testarea proprietatilor fizico-mecanice, de curgere in topitura si activitate antimicrobiana;
- Selectarea recepturilor cu activitate antimicrobiana evident, in vederea prelucrarii tubulaturilor coextrudate;
- Realizarea granulelor din recepturile selectate;
- Coextrudarea in vederea obtinerii de tubulaturi cu strat exterior antimicrobian.
Tubulaturile stratificate au fost obtinute prin metoda de impregnare prin imersare in solutie apoasa de azotat de argint. Aceeasi metoda a fost aplicata epruvetelor plane din materialele martor, pentru a fi analizate din punct de vedere al proprietatilor fizico-mecanice, sterilitatii si unghiul de contact. Recepturile martor au fost analizate din punct de vedere al pierderii de plastifiant.
O activitate esentiala a etapei o reprezinta testarea activității antimicrobiene și a biocompatibilității unor suprafețe pe bază de PVC în scopul obținerii unor noi materiale de acoperire a dispozitivelor medicale polimerice.
Nanoparticulele de Ag sunt cunoscute pentru activitatea antimicrobiana pronuntată dependenta de formă si dimensiune. În acest sens, au fost testate diverse rute de sinteză care să induca proprietati antimicrobiene avansate prin controlul celor două caracteristici ale nanoparticulelor. Controlul formei si dimensiunii s-a realizat prin ruta de sinteză propusă: temperatura de lucru (de la temperature camerei la temperature de fierbere a solutiei), agent de reducere (glucoza, citrat sau acid ascorbic), concentratia de precursori (0.001 – 0.1N), natura precursorilor (lactat de argint sau azotat de argint), etc. Dintre probele realizate, activitate antimicrobiana maxima au manifestat probele obtinute utilizand diversi agenti de stabilizare.


Imagini TEM caracteristice
nanoparticulelor de Ag (a. obtinut din AgNO3; b-c. obtinut din
lactat de Ag)

Imagini TEM caracteristice
probelor obţinute prin reducerea azotatului de argint, in prezenta PVA utilizat ca agent de
stabilizare
Diametrele zonelor
de inhibiţie, exprimate
în mm, în urma testării calitative a activităţii antimicrobiene a suspensiilor de nanoparticule
utilizate în peliculizare.
|
Tulpini microbiene
testate |
Diametrul zonelor
de inhibiţie în mm |
||
|
Ag NPS PVP |
Ag NPS PVA |
Ag NPS PVA + Lactat |
|
|
S. aureus ATCC
25922 |
8 |
6 |
4 |
|
S. aureus 35 pl |
8 |
8 |
6 |
|
Ps. aeuruginosa ATCC
27853 |
12 |
12 |
11 |
|
Ps. aeuruginosa 261 |
12 |
10 |
10 |
|
C. albicans 46 |
15 |
16 |
14 |
|
C. albicans 65 |
18 |
16 |
14 |

Aspectul zonelor de inhibiţie în urma testării calitative
a activităţii antimicrobiene
a suspensiilor de nanoparticule
utilizate în peliculizare, faţă de tulpinile de S. aureus 35 (stânga) şi S.
aureus ATCC 25922 (dreapta).

Aspectul zonelor de inhibiţie în urma testării calitative a activităţii antimicrobiene
a suspensiilor de nanoparticule
utilizate în peliculizare, faţă de tulpinile de P. aeruginosa 261 (stânga) şi P. aeruginosa ATCC 27853 (dreapta).
Aspectul zonelor de inhibiţie în urma testării calitative a activităţii antimicrobiene
a suspensiilor de nanoparticule
utilizate în peliculizare, faţă de tulpinile de C. albicans 64 (stânga) şi C.
albicans 45 (dreapta).
Suspensia de nanoparticule
cu activitate microbicidă cu cel mai mare grad de eficienţă
faţă de tulpinile testate a fost Ag NPS PVP, valoarea CMI fiind 19.53
μg/ml în toate cazurile. În schimb, nanoparticulele codificate Ag NPS PVA-lactat au manifestat
acţiune inhibitorie la concentraţii mai mari faţa de tulpinile
bacteriene Gram pozitive de S. aureus.

Reprezentarea grafică a
valorilor CMI ale suspensiilor de nanoparticule utilizate în etapa de
peliculizare a biomaterialelor selectate.
Realizare recepturi polimerice, antimicrobiene
In scopul realizarii de dispozitive protetice tubulare prin coextrudare, au fost propuse urmatoarele scheme de recepturi polimerice conform tabelului.
Recepturi polimerice
|
Receptura Material |
P1 m [%] |
P1S3 [%] |
P1B2 [%] |
P2 m [%] |
P2S3 [%] |
P2B2 [%] |
RB [%] |
RBS3 [%] |
RBB2 [%] |
|
PVC |
65 |
63 |
45 |
65 |
63 |
45 |
65 |
63 |
45 |
|
DOP |
- |
- |
- |
- |
- |
- |
30 |
30 |
30 |
|
Proviplast 01422 |
30 |
30 |
30 |
- |
- |
- |
- |
- |
- |
|
Proviplast 2624 |
- |
- |
- |
30 |
30 |
30 |
- |
- |
- |
|
Ulei de soia epoxidat |
1,8 |
1,8 |
2,0 |
2,5 |
1,8 |
1,8 |
1,8 |
1,8 |
1,8 |
|
Stabilizator stearat de Ca |
1,6 |
1,6 |
1,6 |
1,6 |
1,6 |
1,6 |
1,6 |
1,6 |
1,6 |
|
Stabilizator stearat de Zn |
0,4 |
0,4 |
0,4 |
0,4 |
0,4 |
0,4 |
0,4 |
0,4 |
0,4 |
|
Antioxidant Irganox 1076 |
1,2 |
1,2 |
1,2 |
1,2 |
1,2 |
1,2 |
1,2 |
1,2 |
1,2 |
|
Agent antibacterian S3 |
- |
2 |
- |
- |
2 |
- |
- |
2 |
- |
|
Agent antibacterian B2 |
- |
- |
20 |
- |
- |
20 |
- |
- |
20 |
Pentru analiza proprietatilor fizico-mecanice, recepturile experimentale au fost realizate initial la nivel laborator, prin amestecarea materiilor prime in plastograful Brabender Lab-Station, parametrii de amestecare fiind redaţi in tabel.
Parametri de realizare a recepturilor polimerice in plastograful Brabender
|
Receptura |
Temperatura [oC] |
Turatie snecuri [rot/min] |
Durata [minute] |
|
P1 m |
170 |
75 |
10 |
|
P1S3 |
175 |
80 |
10 |
|
P1B2 |
173 |
78 |
10 |
|
P2 m |
172 |
79 |
10 |
|
P2S3 |
175 |
81 |
10 |
|
P2B2 |
176 |
80 |
10 |
|
RB |
170 |
75 |
10 |
|
RB S3 |
175 |
80 |
10 |
|
RB B2 |
173 |
78 |
10 |
Imaginile de microscopie FTIR pot fi utilizate
pentru analiza dispozitivelor tubulare protetice. Imaginea video permite
analiza dispozitivului tubular, la nivel macroscopic. In sectiune, de asemenea s-a
analizat, pe baza benzii de la 2965, 1747, 1301, 1150, 1086cm-1 sau
la orice alta banda de absorbtie caracteristica PVC-ului. Pe baza imaginii FTIR
se poate observa omogenitatea compozitională a materialului, zonele rosii
din perete fiind caracteristice unor defecte (denivelări corespunzând
zonelor de tip deal-vale). (imaginea FTIR a fost inregistrata doar partial
datorita timpului de achizitie foarte mare necesar).

Figura 1. Imagini de microscopie FTIR caracterisice tuburilor de PVC
Studiul biocompatibilitatii
suprafetelor obtinute
Analiza biocompatibilitatii materialelor obtinute s-a realizat prin studiul in vitro al interactiunii esantioanelor obtinute cu celulele Hep-2 cultivate timp de 24 de ore pe substraturile obtinute si analizate din punct de vedere morfologic. Colorarea monostratului celular de 24 de ore obtinut pe substraturile analizate cu iodura de propidiu a permis evidentierea unor detalii de morfologie ale celulelor aderate, ce confirma aspectul normal al acestora si proliferarea activa pe suprafetele investigate, evidentiata prin prezenta a numeroase celule in metafaza.
|
PIS1 |
P2 |
P2S1 |
P2S3 |
P2B1 |
P2B2 |
RB |
Imagini de microscopie
de fluorescenta ale monostratului
de celule Hep-2 dezvoltate pe suprafatele materialelor testate.
Studiul activitatii
antibiofilm a materialelor testate
prin punerea lor in contact direct cu tulpinile microbiene a relevat faptul ca dupa 24 de ore s-a constatat inhibarea
semnificativa a dezvoltarii
tulpinilor de B.
subtilis si C.
albicans, pentru toate materialele testate si o diminuare a dezvoltarii biofilmului in cazul tulpinilor de S. aureus si E. faecalis. P1S3 si P2S3, urmate de P1B2 si P2M, in timp ce
materialele P2B2, P2S3, RB si RBB 3 au inhibat in mod semnificativ aderenta E. faecalis.
In cazul tulpinii E. coli nu s-a observat efect
inhibitor, ci unul usor stimulator al cresterii bacteriene in stare aderata.

Activitatea antibiofilm
a materialelor testate cuantificata prin determinarea numarului de UFC imediat dupa
contact si la 24 ore de incubare.
CONCLUZII
In cadrul etapei curente s-a
urmarit realizarea de nanoparticule de Ag cu activitate antimicrobiana precum
si dispozitive protetice dublu strat cu activitate antimicrobiana.
Nanoparticulele de Ag au
fost obtinute prin diverse rute de sinteză care să induca proprietati
antimicrobiene avansate prin controlul celor două caracteristici ale
nanoparticulelor: forma şi dimensiune. Controlul formei si dimensiunii s-a
realizat prin ruta de sinteză propusă: temperatura de lucru (de la
temperature camerei la temperature de fierbere a solutiei), agent de reducere
(glucoza, citrat sau acid ascorbic), concentratia de precursori (0.001 – 0.1N),
natura precursorilor (lactat de argint sau azotat de argint) sau agentul de
stabilizare utilizat (PVA, PVP, Stearat, etc).
Dispozitivele antimicrobiene
au fost obtinute prin doua metode diferite. Prin co-extrudare au fost obtinute
obtinute dispozitive cu o suprafata antimicrobiana asigurata de prezenţa
nanoparticulelor de Ag, utilizând polimeri comerciali cu continut variat de
nanoparticule de Ag sau, prin depunerea de nanoparticule de Ag pe
suprafaţa modelelor experimentale testate.
In cadrul primei activitati au fost realizate prin compoundare si granulare, trei tipuri de recepturi pe baza de PVC plastifiat cu di-2-etilhexilftalat (DOP), bis(2-(2-butoxietoxi)etil)adipat (sort Proviplast 01422) si tributil 2-acetilcitrat (sort Proviplast 2624) codificate P1m, P2m, RB, in scopul minimizarii pierderii de plastifiant, fenomen ce are loc pe perioada utilizarii in contact prelungit cu corpul uman sau pe perioada depozitarii. Pentru o evaluare corecta a proprietatilor fizico-mecanice, s-a optat pentru cantitati identice ale plastifiantilor in recepturi. In paralel au fost realizate aceleasi recepturi dar cu continut de aditiv antimicrobian pe baza de nanoparticule de argint inglobate in matrice ceramica sau in matrice de copolimer etilen vinilacetat.
Intr-o prima etapa granulele de recepturi au fost prelucrate prin presare pe
presa Fontune Press, rezultand placi cu grosime de 1mm si filme din care au fost prelevate epruvete standardizate. Au fost analizate rezistenta la tractiune, alungirea la rupere,
Densitatea si indicele de curgere in topitura, impreuna cu proprietatile termice determinate prin analiza DSC, de unde au rezultat temperaturile de tranzitie vitroasa si de topire ale recepturilor pe baza de PVC, au oferit datele necesare proiectarii tehnologiei de prelucrare prin coextrudare.
Au fost realizate testari
ale proprietatilor de biocompatibilitate si activitate antimicrobiana,
In lucrare au fost
prezentate conditiile tehnologice pentru obtinere tubulaturi coextrudate, a
caror structura a fost:
-
stratul
exterior compus din polimer cu aditiv antimicrobian,
-
stratul
interior compus din polimer martor.
Durata optima de viata a
dispozitivelor protetice tubulare stratificate a fost analizata prin teste de
imbatranire accelerata timp de 7 zile la temperatura de 100oC.
Rezultatele au aratat ca o imbatranire mai accentuata a materialului si
implicit alterarea proprietatilor fizico-mecanice, au fost observate pentru
recepturile in care aditivul antimicrobian a fost incapsulat in matrice de
copolimer etilen vinilacetat. Totusi, variatiile de proprietate s-au incadrat
in limita celor 10% admise de standard.
In a doua activitate a
etapei, recepturile pe baza de PVC plastifiat codificate P1m, P2m si RB au fost
prelucrate prin tehnologia de extrudare, rezultand tubulaturi monostrat. Pentru
obtinerea de dispozitive stratificate, acestea au fost supuse modificarii
suprafetelor in contact cu solvent ciclohexanona si apoi au fost impregnate
prin imersare in solutie apoasa preparata prin
amestecarea timp de 10 minute 5.6 g/L zaharina de sodiu 20,
Probele obtinute au fost
analizate din punct de vedere al proprietatilor fizico-mecanice, termice si
sterilitatii. Valorile obtinute au condus la urmatoarea clasificare:
-
rezistenta
la tractiune: P2m > RB > P1m;
-
alungirea
la rupere: RB > P2 > P1;
-
duritate Shore A: P2m > P1m > RB;
-
pierdere de plastifiant: RB > P1m > P2m.
Toate probele s-au
sterilizat cu oxid de etilena.
Avand in vedere rezultatele
obtinute, se poate afirma ca utilizarea plastifiantilor pe baza de adipat,
citrat si ftalat in recepturi de PVC de uz medical, impreuna cu stabilizatori
termici, antioxidanti si aditivi antimicrobieni au condus la realizarea unor
compounduri ale caror proprietati termice, au permis prelucrarea in topitura
prin tehnologia de extrudare si coextrudare tubulaturi monostrat si dublustrat.
Proprietatile
fizico-mecanice determinate s-au incadrat in normele impuse standardelor de
produs, admitand ca toate recepturile pot fi utilizate la prelucrarea in tubulaturi
medicale. Din comparatia lor, se poate admite ca recepturile plastifiate cu
citrat sunt superioare celor plastifiate cu adipat si ftalat.
Investiţii în infrastructură: 262.698 + 98.069+24.003 RON adică 384.770RON
Applicaţii de
brevet înregistrate la OSIM:
1.
Elena
GROSU, Anton FICAI, Maria RAPA, Sorin ULINICI, Denisa FICAI, Ecaterina
ANDRONESCU, Carmen BALOTESCU, Lia Mara DITU; Dispozitiv protetic tubular
stratificat cu proprietati antimicrobiene; OSIM A/00904/25.11.2014.
Participare conferinţe:
1.
Elena
GROSU, Anton FICAI, Maria RAPA,
Grigore VLAD, Luiza JECU; Selecting medical grade polymers and testing for
achieving antibacterial devices tubular prosthetic; International Conference on Materials Science & Engineering –
BRAMAT 2013, 28.02–2.03 2013, BRAŞOV, ROMANIA;
2.
Participare la Simpozion PRIORICHEM, organizat
de ICECHIM, perioada 24-25.10.2013, Bucuresti, cu lucrarea “TESTING OF ANTIBACTERIAL
AND ANTIBIOFILM NANOSTRUCTURED MATERIALS FOR STRATIFIED PROSTETHIC TUBULAR
DEVICES” autori: Elena Grosu, Anton Ficai, Maria Rapa, Grigore Vlad,
Luiza Jecu, Petruta Stoica
3.
Participare la Simpozion Environment&Progress organizat de Universitatea Babes-Bolyai Facultatea Stiinta si Ingineria
Mediului si S.C. ICPE Bistrita S.A., in perioada
25.10.2013, Cluj, cu lucrarea
“ELIMINAREA FACTORILOR DE RISC ÎN TIMPUL UTILIZĂRII DISPOZITIVELOR
PROTETICE TUBULARE, PRIN MODIFICAREA PROPRIETAŢILOR SUPRAFEŢELOR
ACESTORA”, autori: Elena Grosu, Anton Ficai, Maria Râpă, Grigore Vlad, Petruţa Stoica
4.
Elena GROSU, Anton FICAI, Laura ALEXANDRESCU, Maria SONMEZ, Maria RAPA, Mihaela HETVARY, Mihaela
ANDREICA, Luiza JECU, Environmental
safety plastified compounds of polyvinyl chloride for
antimicrobial medical devices, ELSEDIMA International
Conference – 18-19 September 2014, Cluj-Napoca, Romania;
5.
Elena
GROSU, Anton FICAI, Carmen BALOTESCU, Maria RAPA, Petruta
STOICA, Luiza JECU, Mihaela
ANDREICA, Mihaela HETVARI; Antibacterial nanostructured medical devices, International Symposium - “PRIORITIES OF CHEMISTRY FOR A SUSTAINABLE
DEVELOPMENT”, PRIOCHEM, 10th Edition, ROMANIA – Bucharest, October 30th – 31th, 2014;
6.
Oana Cristina DUTA, Denisa FICAI,
Anton FICAI, Ecaterina ANDRONESCU, Roxana TRUSCA,
Madalina Georgiana ALBU, Marius RADULESCU, Grigore MIHAESCU, Lia Mara DITU; Synthesis of
antimicrobial materials with regenerative function by LBL method; Proceedings of the 4th International Conference on
Advanced Materials and Systems, ICAMS 2014, 6pag
Publicare de articole:
1.
Dan
Eduard MIHAIESCU, Alexandru
Mihai GRUMEZESCU, Ecaterina ANDRONESCU, Georgeta
Voicu, Anton FICAI, Otilia Ruxandra
VASILE, Coralia BLEOTU and Crina SAVIUC; Prosthetic Devices with Functionalized
Anti-biofilm Surface Based NanoAg@C18; Current
Organic Chemistry, 2013, 17, 105-112;
2.
Voicu, G; Andronescu, E; Grumezescu, AM; Huang, KS; Ficai, A; Yang, CH; Bleotu, C; Chifiriuc,
MC; Antitumor Activity of
Magnetite Nanoparticles: Influence of Hydrocarbonated
Chain of Saturated Aliphatic Monocarboxylic Acids;
Current Organic Chemistry: 2013:17(8):831-840;
3.
Alexandru Mihai GRUMEZESCU; Essential Oils and Nanotechnology for
Combating Microbial Biofilms; Current
Organic Chemistry, 2013, 17, 90-96;
4. Ion ANGHEL, Carmen LIMBAN, Alexandru Mihai GRUMEZESCU, Alina Georgiana ANGHEL, Coralia BLEOTU, Mariana Carmen CHIFIRIUC; In vitro evaluation of anti-pathogenic surface coating nanofluid, obtained by combining FeO4/C12 nanostructures and 2-((4-ethylphenoxy) methyl)-N-(substituted-phenylcarbamothioyl)-benzamides; Nanoscale Research Letters 2012, 7:513;
5.
Ion ANGHEL, Alexandru Mihai
GRUMEZESCU, Ecaterina ANDRONESCU, Alina Georgiana ANGHEL, Anton FICAI, Crina
SAVIUC, Valentina GRUMEZESCU, Bogdan Stefan VASILE, Mariana Carmen CHIFIRIUC;
Magnetite nanoparticles for functionalized textile dressing to prevent fungal
biofilms development; Nanoscale Research Letters: 2012;7(1):501-506;
6.
Ion
ANGHEL, Alina Maria HOLBAN, Ecaterina ANDRONESCU, Alexandru Mihai GRUMEZESCU, Mariana Carmen CHIFIRIUC;
Efficient surface functionalization of wound dressings by a phytoactive
nanocoating refractory to Candida albicans
biofilm development; Biointerphases 2013, 8:12-20;
7.
Ion
ANGHEL and Alexandru Mihai GRUMEZESCU; Hybrid nanostructured coating for increased resistance of
prosthetic devices to staphylococcal colonization; Nanoscale
Research Letters 2013, 8:6;
8.
PC Balaure; E Andronescu; AM Grumezescu; A Ficai; KS Huang; CH Yang; CM Chifiriuc;
YS Lin; Fabrication, characterization and in vitro profile based interaction
with eukaryotic and prokaryotic cells of alginate-chitosan-silica
biocomposite; International Journal of pharmaceutics;
2013:441(1-2):555-561;
9. Madalina Georgiana FLOREA, Ioan-Avram NEDELCU, Camelia UNGUREANU, Anton FICAI, Denisa FICAI, Cornelia GURAN, Ecaterina ANDRONESCU; Alginate and sulfanilamide based DDS with antibacterial activity; International Journal of Polymeric Materials and Polymeric Biomaterials, 2013:accepted paper;
10.
Elena GROSU, Anton FICAI,
Maria RAPA, Grigore VLAD, Luiza JECU;
Selecting medical grade polymers and testing for
achieving antibacterial devices tubular prosthetic, Journal of
Optoelectronics and Advanced Materials, under review;
11.
Grumezescu
AM, Ghitulica CD, Voicu G, et al. New silica
nanostructure for the improved delivery of topical antibiotics used in the
treatment of staphylococcal cutaneous infections. International
Journal of Pharmaceutics. Mar 25 2014;463(2):170-176;
12.
Oana Cristina DUTA, Denisa FICAI,
Anton FICAI, Ecaterina ANDRONESCU, Roxana TRUSCA,
Madalina Georgiana ALBU, Marius RADULESCU, Grigore MIHAESCU, Lia Mara DITU; Synthesis of
antimicrobial materials with regenerative function by LBL method; Proceedings of the 4th International Conference on
Advanced Materials and Systems, ICAMS 2014, 6pag (acceptat
spre publicare);